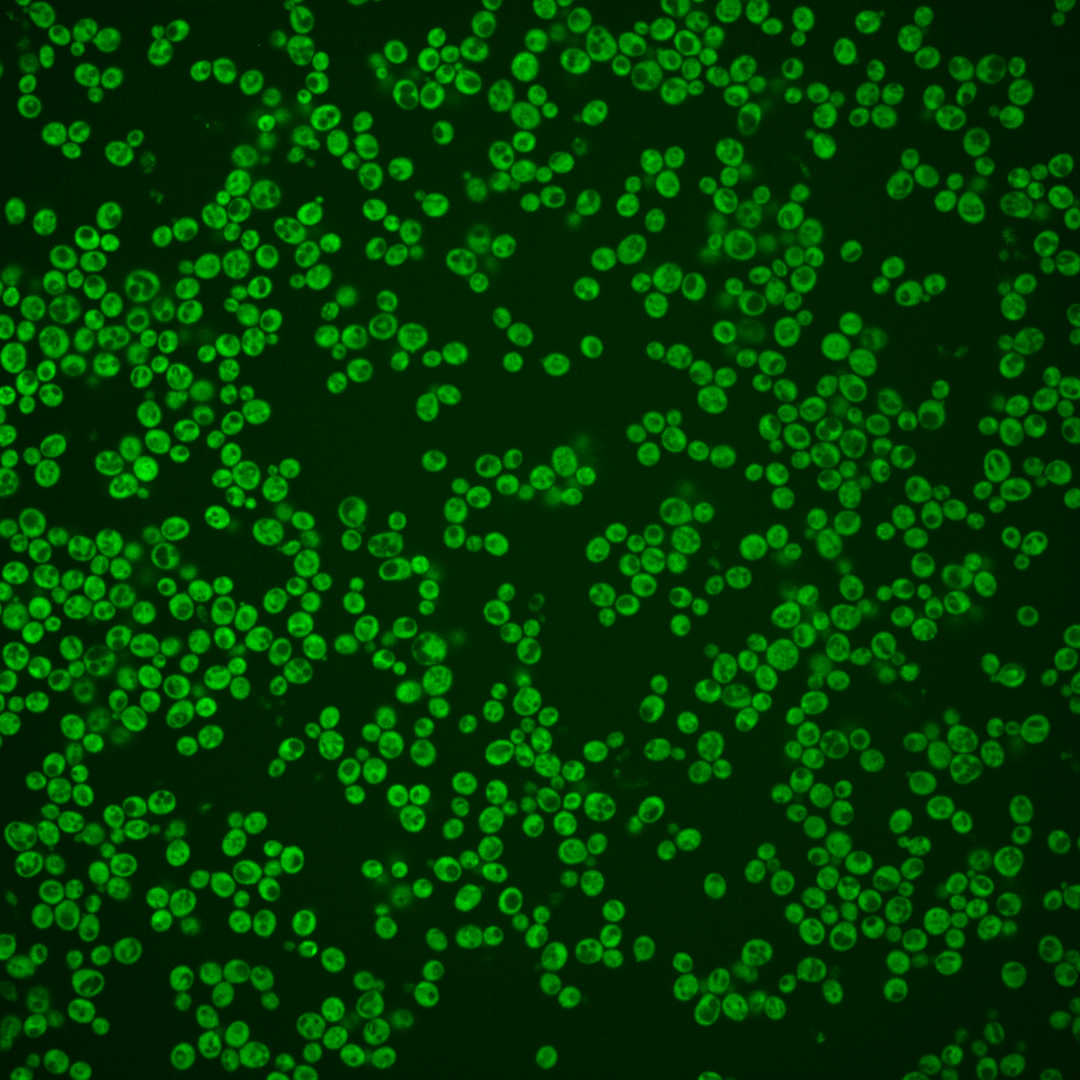
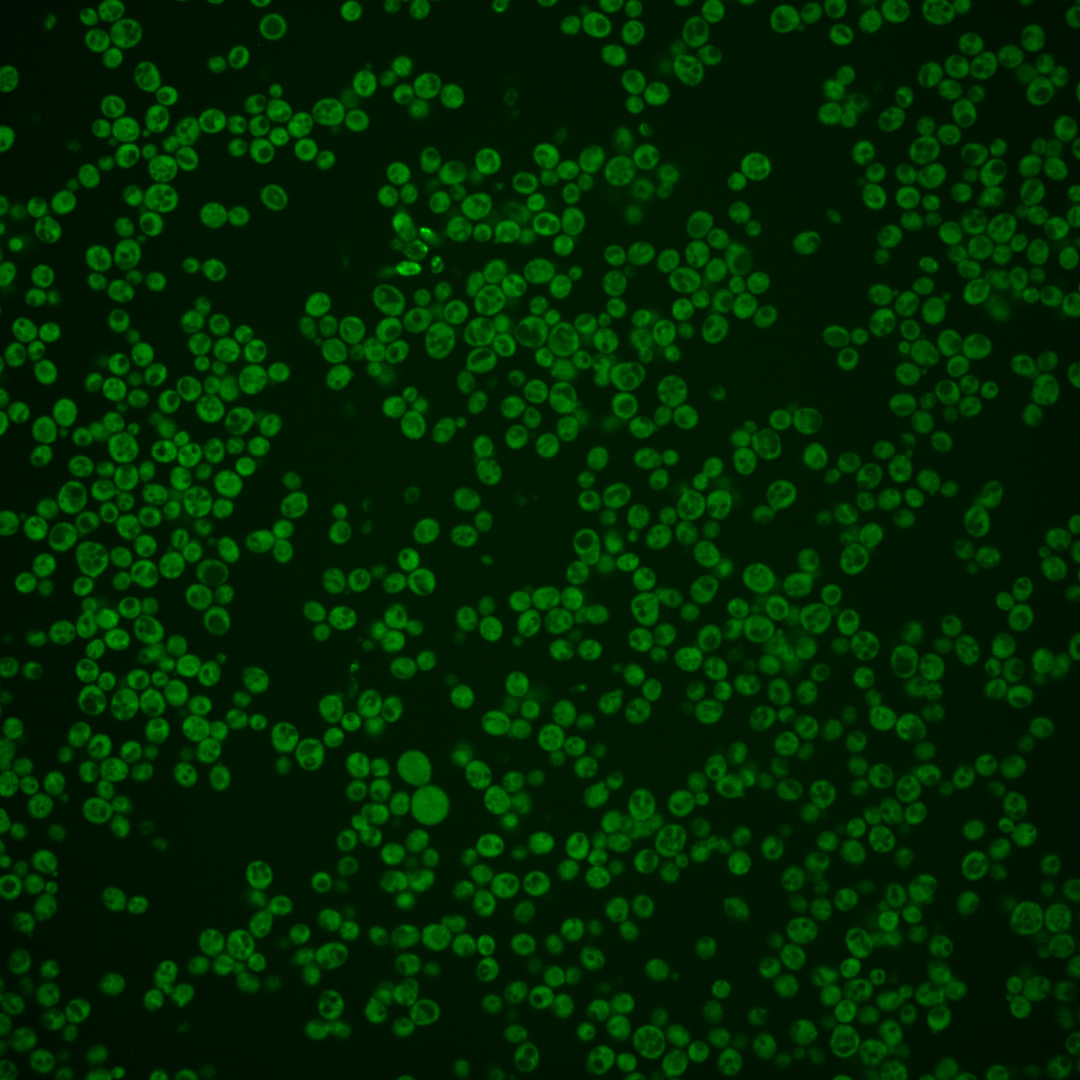
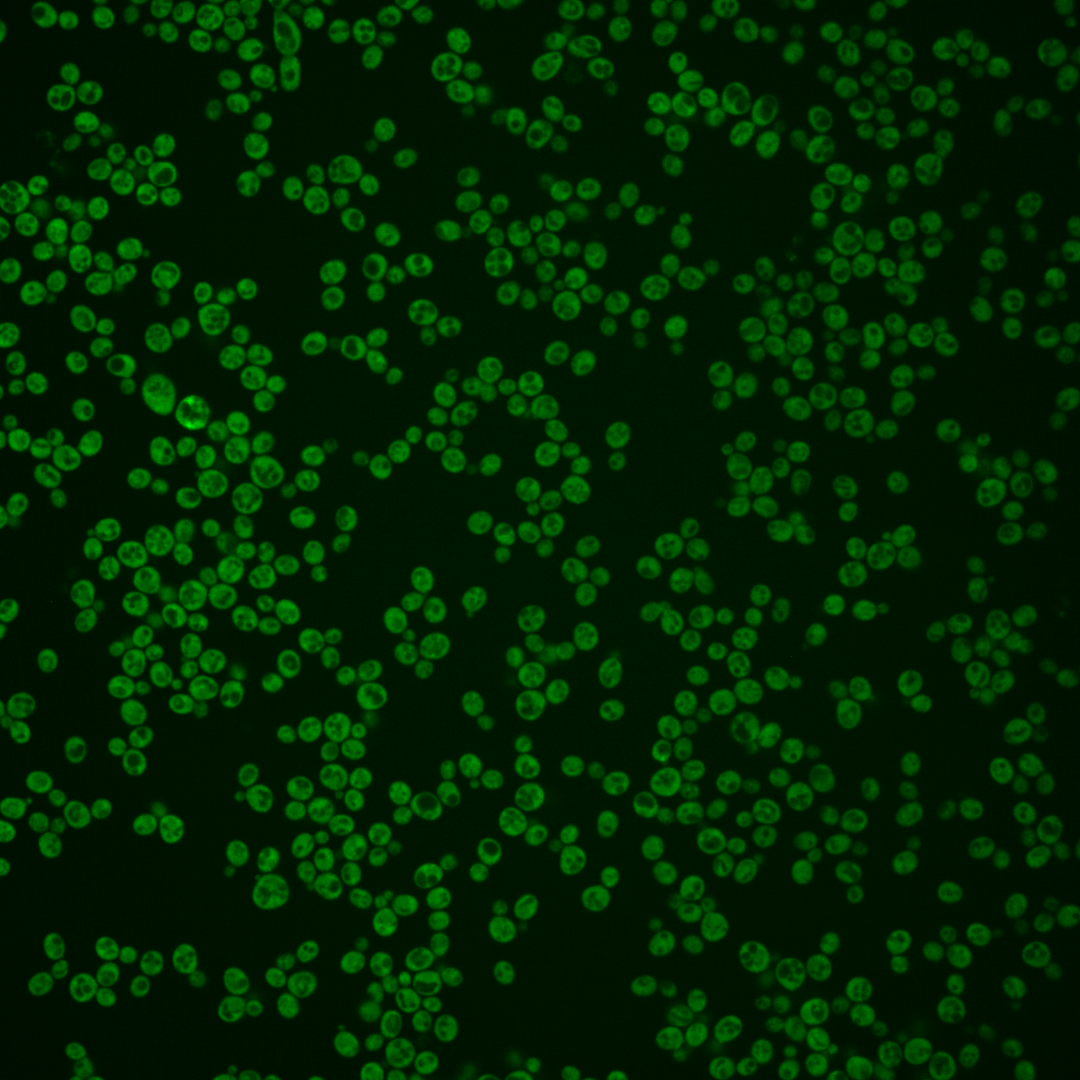
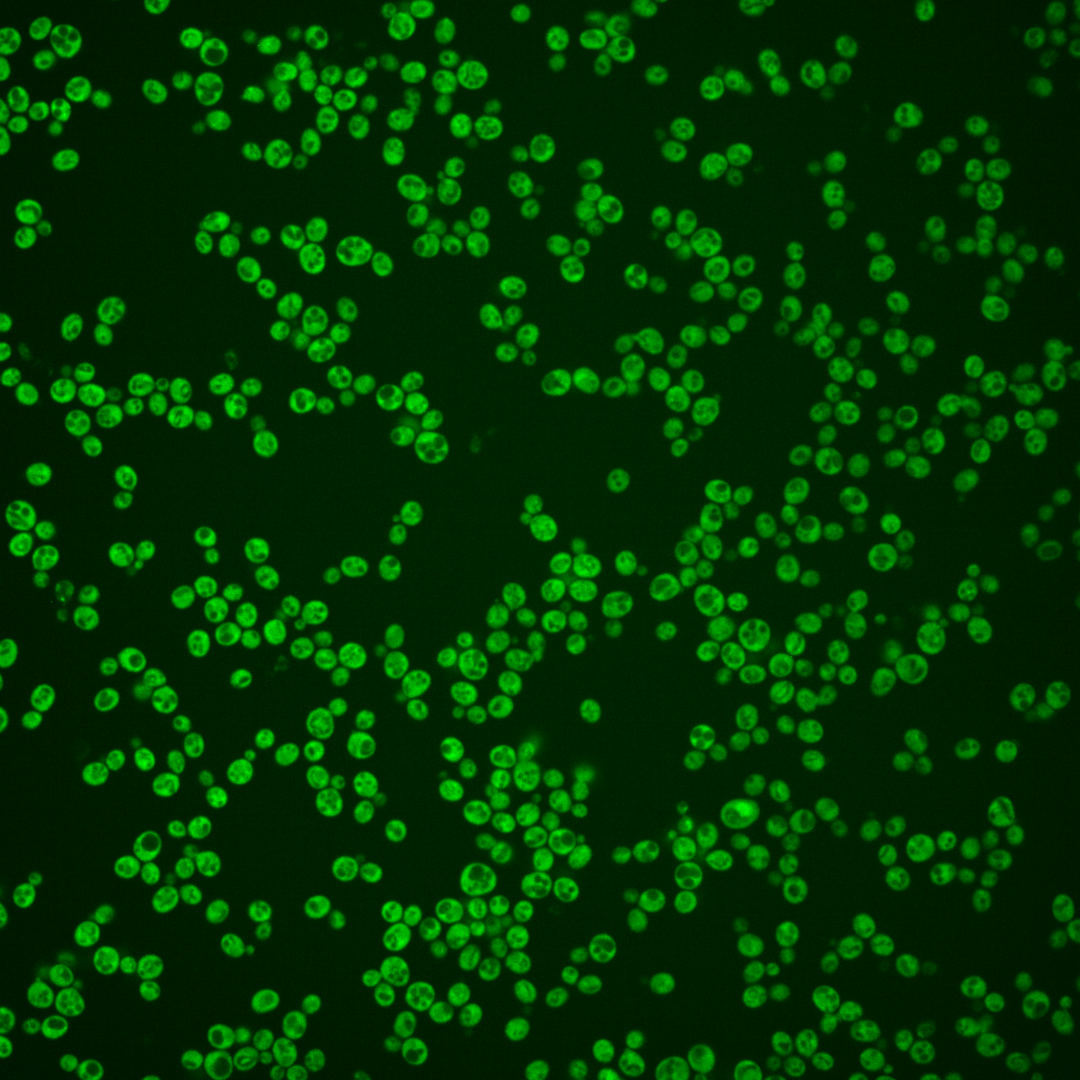
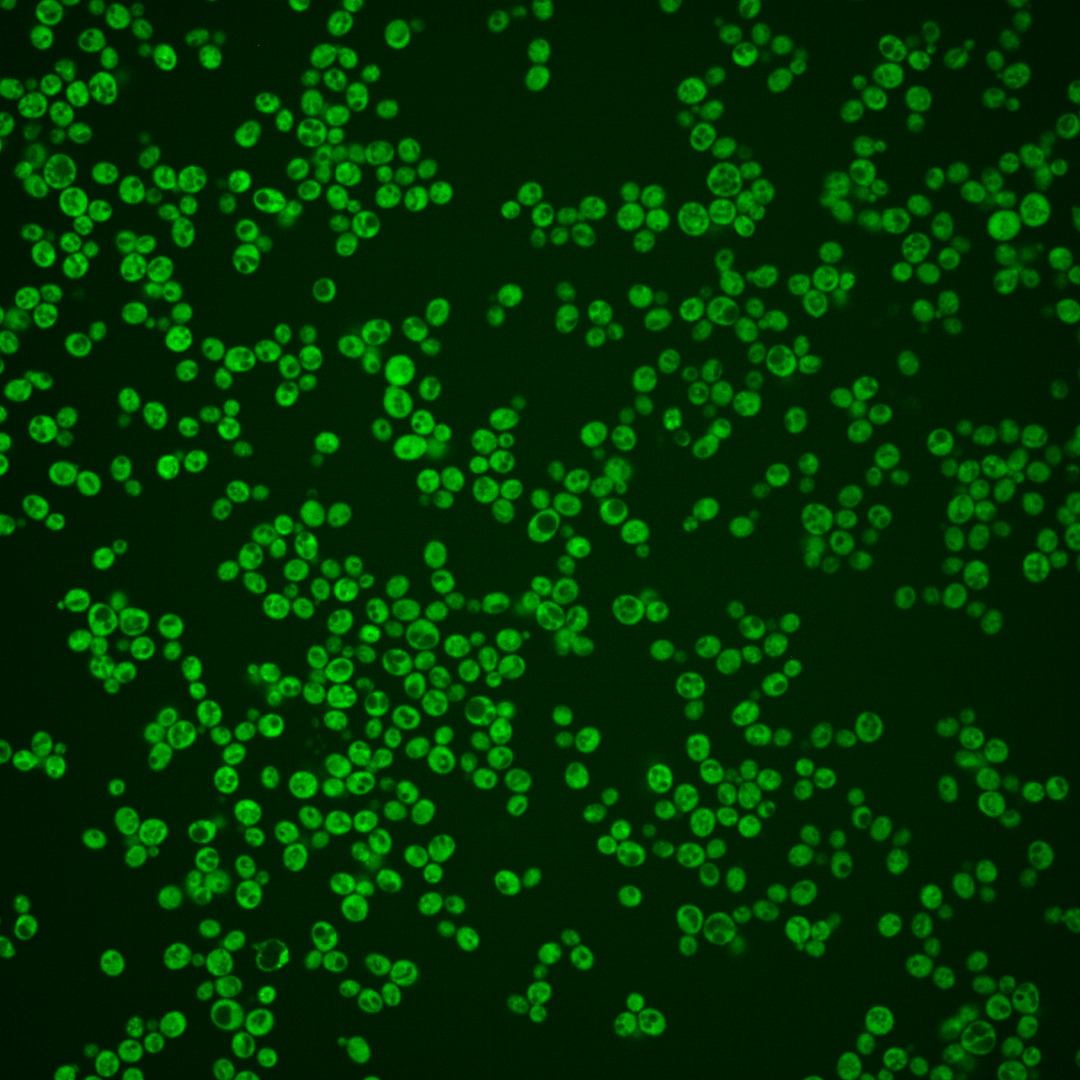

| Standard name | |
|---|---|
| Human Ortholog | |
| Description | RNA binding protein that sequesters CLN3 mRNA in cytoplasmic foci; regulates genes involved in the cell cycle, sister chromatid cohesion, and stress response; acts as a cytoplasmic retention factor for Cdc28p and associated cyclins; regulates cell fate and dose-dependently regulates the critical cell size required for passage through Start; Tpk1p (PKA) mediated phosphorylation (S568) inhibits Whi3p function, decreasing its interaction with CLN3 mRNA; regulates ploidy |
Micrographs




















































































Sub-cellular Localization
Yeast GFP Assignment
Protein Abundance
Localization Change
External localization resources
| ensLOC | DeepLoc | |||||||||||||||||||||||
|---|---|---|---|---|---|---|---|---|---|---|---|---|---|---|---|---|---|---|---|---|---|---|---|---|
| Localization | WT1 | WT2 | WT3 | RAP60 | RAP140 | RAP220 | RAP300 | RAP380 | RAP460 | RAP540 | RAP620 | RAP700 | HU80 | HU120 | HU160 | rpd3Δ_1 | rpd3Δ_2 | rpd3Δ_3 | WT1 | WT2 | WT3 | AF100 | AF140 | AF180 |
| Cortical Patches | 0 | 0 | 0 | 1 | 2 | 12 | 28 | – | 21 | 20 | 15 | 9 | 0 | 1 | 4 | – | – | – | 0 | 0 | 1 | 0 | 0 | 0 |
| Bud | 0 | 0 | 0 | 0 | 0 | 0 | 2 | – | 0 | 0 | 1 | 5 | 0 | 1 | 0 | – | – | – | 0 | 0 | 0 | 0 | 1 | 0 |
| Bud Neck | 0 | 0 | 0 | 0 | 0 | 0 | 0 | – | 0 | 0 | 0 | 0 | 0 | 0 | 0 | – | – | – | 0 | 0 | 0 | 0 | 0 | 0 |
| Bud Site | 0 | 0 | 0 | 0 | 0 | 0 | 0 | – | 0 | 0 | 0 | 0 | 0 | 0 | 0 | – | – | – | – | – | – | – | – | – |
| Cell Periphery | 1 | 2 | 6 | 7 | 8 | 19 | 30 | – | 24 | 32 | 17 | 21 | 1 | 9 | 19 | – | – | – | 0 | 0 | 0 | 0 | 0 | 0 |
| Cytoplasm | 174 | 113 | 147 | 221 | 320 | 361 | 468 | – | 273 | 319 | 216 | 209 | 133 | 272 | 360 | – | – | – | 163 | 115 | 142 | 84 | 207 | 224 |
| Endoplasmic Reticulum | 3 | 4 | 6 | 10 | 26 | 54 | 92 | – | 76 | 86 | 34 | 49 | 3 | 8 | 11 | – | – | – | 5 | 3 | 13 | 2 | 3 | 4 |
| Endosome | 0 | 0 | 0 | 0 | 1 | 1 | 2 | – | 0 | 2 | 1 | 1 | 0 | 1 | 1 | – | – | – | 0 | 0 | 0 | 0 | 0 | 1 |
| Golgi | 0 | 0 | 0 | 0 | 7 | 2 | 4 | – | 2 | 3 | 4 | 6 | 0 | 0 | 0 | – | – | – | 0 | 0 | 1 | 0 | 0 | 0 |
| Mitochondria | 0 | 0 | 1 | 0 | 3 | 18 | 29 | – | 20 | 22 | 57 | 66 | 0 | 0 | 0 | – | – | – | 0 | 0 | 1 | 0 | 0 | 0 |
| Nucleus | 1 | 0 | 2 | 0 | 0 | 0 | 0 | – | 2 | 0 | 0 | 0 | 1 | 1 | 1 | – | – | – | 0 | 0 | 0 | 0 | 1 | 0 |
| Nuclear Periphery | 0 | 0 | 0 | 1 | 0 | 0 | 0 | – | 0 | 2 | 0 | 1 | 1 | 0 | 0 | – | – | – | 0 | 1 | 0 | 1 | 0 | 0 |
| Nucleolus | 0 | 0 | 0 | 0 | 0 | 0 | 0 | – | 0 | 0 | 0 | 2 | 0 | 1 | 0 | – | – | – | 0 | 0 | 0 | 0 | 0 | 0 |
| Peroxisomes | 0 | 0 | 0 | 0 | 0 | 0 | 0 | – | 0 | 0 | 0 | 0 | 0 | 0 | 0 | – | – | – | 0 | 0 | 0 | 0 | 0 | 0 |
| SpindlePole | 0 | 0 | 0 | 0 | 0 | 0 | 0 | – | 0 | 0 | 0 | 0 | 0 | 0 | 0 | – | – | – | 0 | 0 | 0 | 0 | 0 | 0 |
| Vac/Vac Membrane | 0 | 0 | 1 | 1 | 20 | 8 | 28 | – | 5 | 6 | 7 | 33 | 0 | 1 | 0 | – | – | – | 1 | 2 | 5 | 1 | 2 | 0 |
| Unique Cell Count | 177 | 116 | 156 | 233 | 368 | 433 | 617 | 376 | 447 | 308 | 354 | 138 | 282 | 372 | 173 | 126 | 172 | 93 | 220 | 236 | ||||
| Labelled Cell Count | 179 | 119 | 163 | 241 | 387 | 475 | 683 | 423 | 492 | 352 | 402 | 139 | 295 | 396 | 173 | 126 | 172 | 93 | 220 | 236 | ||||
Yeast GFP Assignment
Protein Abundance
| Screen | WT1 | WT2 | WT3 | RAP60 | RAP140 | RAP220 | RAP300 | RAP380 | RAP460 | RAP540 | RAP620 | RAP700 | HU80 | HU120 | HU160 | rpd3Δ_1 | rpd3Δ_2 | rpd3Δ_3 | AF100 | AF140 | AF180 |
|---|---|---|---|---|---|---|---|---|---|---|---|---|---|---|---|---|---|---|---|---|---|
| Mean Cell GFP Intensity (1e-4) | 12.8 | 16.0 | 12.5 | 12.6 | 13.7 | 12.3 | 12.4 | – | 11.7 | 12.2 | 11.7 | 11.7 | 13.1 | 13.4 | 12.8 | – | – | – | 10.0 | 12.0 | 12.0 |
| Std Deviation (1e-4) | 1.5 | 2.5 | 2.3 | 1.6 | 1.9 | 1.8 | 1.9 | – | 1.9 | 2.1 | 9.0 | 4.6 | 2.2 | 1.8 | 1.7 | – | – | – | 1.6 | 1.6 | 1.7 |
| Intensity Change (Log2) | – | – | – | 0.01 | 0.13 | -0.03 | -0.01 | – | -0.1 | -0.03 | -0.1 | -0.1 | 0.07 | 0.1 | 0.03 | – | – | – | -0.32 | -0.06 | -0.06 |
Localization Change
| Localization | RAP60 | RAP140 | RAP220 | RAP300 | RAP380 | RAP460 | RAP540 | RAP620 | RAP700 | HU80 | HU120 | HU160 | rpd3Δ_1 | rpd3Δ_2 | rpd3Δ_3 |
|---|---|---|---|---|---|---|---|---|---|---|---|---|---|---|---|
| Cortical Patches | 0 | 0 | 0 | 2.7 | – | 3.0 | 2.7 | 2.8 | 0 | 0 | 0 | 0 | – | – | – |
| Bud | 0 | 0 | 0 | 0 | – | 0 | 0 | 0 | 0 | 0 | 0 | 0 | – | – | – |
| Bud Neck | 0 | 0 | 0 | 0 | – | 0 | 0 | 0 | 0 | 0 | 0 | 0 | – | – | – |
| Bud Site | 0 | 0 | 0 | 0 | – | 0 | 0 | 0 | 0 | 0 | 0 | 0 | – | – | – |
| Cell Periphery | -0.5 | 0 | 0.3 | 0.5 | – | 1.2 | 1.5 | 0.8 | 1.0 | 0 | -0.4 | 0.6 | – | – | – |
| Cytoplasm | 0.3 | -2.4 | -3.4 | -5.1 | – | -5.6 | -5.9 | -5.9 | -8.0 | 0.9 | 1.1 | 1.4 | – | – | – |
| Endoplasmic Reticulum | 0.2 | 1.4 | 3.1 | 3.7 | – | 4.8 | 4.6 | 2.6 | 3.4 | 0 | 0 | -0.5 | – | – | – |
| Endosome | 0 | 0 | 0 | 0 | – | 0 | 0 | 0 | 0 | 0 | 0 | 0 | – | – | – |
| Golgi | 0 | 0 | 0 | 0 | – | 0 | 0 | 0 | 0 | 0 | 0 | 0 | – | – | – |
| Mitochondria | 0 | 0 | 2.1 | 2.3 | – | 2.5 | 2.4 | 5.5 | 5.5 | 0 | 0 | 0 | – | – | – |
| Nucleus | 0 | 0 | 0 | 0 | – | 0 | 0 | 0 | 0 | 0 | 0 | 0 | – | – | – |
| Nuclear Periphery | 0 | 0 | 0 | 0 | – | 0 | 0 | 0 | 0 | 0 | 0 | 0 | – | – | – |
| Nucleolus | 0 | 0 | 0 | 0 | – | 0 | 0 | 0 | 0 | 0 | 0 | 0 | – | – | – |
| Peroxisomes | 0 | 0 | 0 | 0 | – | 0 | 0 | 0 | 0 | 0 | 0 | 0 | – | – | – |
| SpindlePole | 0 | 0 | 0 | 0 | – | 0 | 0 | 0 | 0 | 0 | 0 | 0 | – | – | – |
| Vacuole | 0 | 2.6 | 0 | 2.3 | – | 0 | 0 | 0 | 3.6 | 0 | 0 | 0 | – | – | – |
External localization resources
Images






























Protein Concentration and Protein Localization Data
| R1 | R2 | R3 | ||||||||||||||||
|---|---|---|---|---|---|---|---|---|---|---|---|---|---|---|---|---|---|---|
| G1 Pre-START | G1 Post-START | S/G2 | Metaphase | Anaphase | Telophase | G1 Pre-START | G1 Post-START | S/G2 | Metaphase | Anaphase | Telophase | G1 Pre-START | G1 Post-START | S/G2 | Metaphase | Anaphase | Telophase | |
| Concentration | 7.105 | 9.3345 | 8.3938 | 6.7759 | 8.0097 | 8.205 | 8.9671 | 11.2909 | 10.8406 | 11.0384 | 9.6079 | 10.6204 | 8.5335 | 10.5263 | 10.0129 | 10.0975 | 10.026 | 9.9932 |
| Actin | 0.0219 | 0.0006 | 0.0122 | 0.0034 | 0.0007 | 0.0057 | 0.0077 | 0.0006 | 0.006 | 0.0006 | 0.0056 | 0.0056 | 0.0029 | 0.0004 | 0.0012 | 0.0008 | 0.0005 | 0.0006 |
| Bud | 0.001 | 0.0004 | 0.0015 | 0.001 | 0.0003 | 0.0006 | 0.0023 | 0.0003 | 0.0006 | 0.0013 | 0.0007 | 0.0008 | 0.0006 | 0.0003 | 0.0004 | 0.0014 | 0.0004 | 0.0002 |
| Bud Neck | 0.0006 | 0.0003 | 0.0007 | 0.0007 | 0.0005 | 0.0015 | 0.002 | 0.0002 | 0.0005 | 0.0007 | 0.0008 | 0.001 | 0.0004 | 0.0002 | 0.0004 | 0.0006 | 0.0004 | 0.001 |
| Bud Periphery | 0.0017 | 0.0001 | 0.0011 | 0.0003 | 0 | 0.0004 | 0.0018 | 0.0001 | 0.0005 | 0.0008 | 0.0009 | 0.0008 | 0.0005 | 0 | 0.0005 | 0.0008 | 0.0001 | 0.0001 |
| Bud Site | 0.0061 | 0.0006 | 0.0009 | 0.0008 | 0.0001 | 0.0003 | 0.0051 | 0.0007 | 0.0018 | 0.0004 | 0.0039 | 0.0002 | 0.0008 | 0.0048 | 0.0003 | 0.0002 | 0.0001 | 0.0001 |
| Cell Periphery | 0.0009 | 0.0003 | 0.0002 | 0.0001 | 0 | 0.0001 | 0.0004 | 0.0001 | 0.0004 | 0.0003 | 0.0002 | 0.0003 | 0.0003 | 0.0001 | 0.0001 | 0.0001 | 0 | 0.0001 |
| Cytoplasm | 0.7117 | 0.9439 | 0.8582 | 0.7041 | 0.8653 | 0.7264 | 0.7347 | 0.9431 | 0.8564 | 0.6934 | 0.7836 | 0.7613 | 0.7819 | 0.9359 | 0.8915 | 0.7904 | 0.8866 | 0.8818 |
| Cytoplasmic Foci | 0.0197 | 0.0104 | 0.012 | 0.0296 | 0.0328 | 0.0297 | 0.0286 | 0.0096 | 0.0146 | 0.0128 | 0.0228 | 0.0168 | 0.0161 | 0.0114 | 0.0128 | 0.0228 | 0.0164 | 0.0156 |
| Eisosomes | 0.0007 | 0 | 0.0001 | 0 | 0 | 0 | 0.0002 | 0 | 0.0001 | 0 | 0.0001 | 0 | 0.0001 | 0 | 0 | 0 | 0 | 0 |
| Endoplasmic Reticulum | 0.0854 | 0.0089 | 0.0219 | 0.0034 | 0.0038 | 0.0413 | 0.0801 | 0.0196 | 0.0283 | 0.0472 | 0.0052 | 0.0946 | 0.0874 | 0.0148 | 0.0242 | 0.0468 | 0.0141 | 0.0426 |
| Endosome | 0.0757 | 0.0234 | 0.0394 | 0.1245 | 0.0861 | 0.1081 | 0.0562 | 0.0175 | 0.0437 | 0.1089 | 0.0728 | 0.0745 | 0.0593 | 0.0238 | 0.0444 | 0.0886 | 0.0618 | 0.0421 |
| Golgi | 0.0141 | 0.003 | 0.0044 | 0.0557 | 0.0038 | 0.0323 | 0.0106 | 0.0022 | 0.0085 | 0.0028 | 0.009 | 0.0093 | 0.0064 | 0.0022 | 0.0052 | 0.0049 | 0.0043 | 0.0049 |
| Lipid Particles | 0.0114 | 0.0001 | 0.0007 | 0.0235 | 0.0001 | 0.0011 | 0.0144 | 0.0001 | 0.003 | 0.0003 | 0.0124 | 0.0025 | 0.0015 | 0.0001 | 0.0001 | 0.0001 | 0 | 0.0001 |
| Mitochondria | 0.0211 | 0.0012 | 0.0131 | 0.0158 | 0.0006 | 0.0322 | 0.0098 | 0.0004 | 0.0106 | 0.0039 | 0.0363 | 0.0139 | 0.0088 | 0.0006 | 0.0043 | 0.004 | 0.0024 | 0.0038 |
| None | 0.0021 | 0.0005 | 0.0015 | 0.0004 | 0.0004 | 0.0008 | 0.0026 | 0.0007 | 0.001 | 0.0008 | 0.001 | 0.0011 | 0.0041 | 0.0008 | 0.001 | 0.0006 | 0.0007 | 0.001 |
| Nuclear Periphery | 0.0079 | 0.0009 | 0.0089 | 0.001 | 0.0006 | 0.0029 | 0.0087 | 0.0011 | 0.0024 | 0.0117 | 0.0026 | 0.0035 | 0.0068 | 0.0007 | 0.003 | 0.0036 | 0.0022 | 0.0011 |
| Nucleolus | 0.0002 | 0 | 0.003 | 0.0001 | 0 | 0 | 0.0004 | 0 | 0 | 0 | 0.0006 | 0 | 0.0004 | 0 | 0 | 0 | 0 | 0 |
| Nucleus | 0.0018 | 0.0007 | 0.0077 | 0.0009 | 0.0005 | 0.0011 | 0.0026 | 0.0008 | 0.0011 | 0.0034 | 0.0017 | 0.0015 | 0.0031 | 0.0007 | 0.0013 | 0.0014 | 0.0011 | 0.0009 |
| Peroxisomes | 0.0017 | 0 | 0.0004 | 0.0039 | 0.0001 | 0.0038 | 0.0121 | 0 | 0.0087 | 0.0001 | 0.0131 | 0.0032 | 0.0005 | 0 | 0.0001 | 0.0002 | 0.0001 | 0.0001 |
| Punctate Nuclear | 0.0005 | 0.0001 | 0.0019 | 0.0005 | 0.0001 | 0.0003 | 0.0048 | 0.0001 | 0.0002 | 0.0002 | 0.0018 | 0.0003 | 0.0031 | 0.0001 | 0.0003 | 0.0001 | 0.0001 | 0.0001 |
| Vacuole | 0.0103 | 0.0039 | 0.0079 | 0.0233 | 0.0025 | 0.0067 | 0.012 | 0.0025 | 0.0099 | 0.0834 | 0.0139 | 0.006 | 0.0121 | 0.0025 | 0.0068 | 0.0252 | 0.0059 | 0.0024 |
| Vacuole Periphery | 0.0032 | 0.0008 | 0.0023 | 0.0068 | 0.0016 | 0.0045 | 0.0029 | 0.0005 | 0.0019 | 0.0272 | 0.0111 | 0.0028 | 0.0029 | 0.0006 | 0.0021 | 0.0073 | 0.0027 | 0.0014 |
Sequencing Data
| R1 | R2 | |||||||||
|---|---|---|---|---|---|---|---|---|---|---|
| G1 Post-START | S/G2 | Metaphase | Anaphase | Telophase | G1 Post-START | S/G2 | Metaphase | Anaphase | Telophase | |
| Gene Expression | 30.0019 | 33.2765 | 22.1128 | 29.6245 | 35.2971 | 26.0983 | 40.1742 | 34.402 | 20.8768 | 41.5304 |
| Translational Efficiency | 1.6406 | 1.4478 | 1.3711 | 0.7774 | 0.9862 | 1.6858 | 1.0327 | 1.1377 | 1.4119 | 1.0113 |
Hit Data
| Dataset | Hit |
|---|---|
| Protein Concentration | ✘ |
| Protein Localization | ✘ |
| Gene Expression | ✘ |
| Translational Efficiency | ✘ |
Endocytosis
| Temp | Actin Patch (Sac6-tdTomato) | Cortical Patch (Sla1-GFP) | Late Endosome (Snf7-GFP) | Vacuole (Vph1-GFP) |
|---|---|---|---|---|
| 37℃ | ||||
| RT |
Cell Cycle Omics
CYCLoPs (Whi3-GFP)
| Gene / Allele | Actin Patch (Sac6-tdTomato) | Cortical Patch (Sla1-GFP) | Late Endosome (Snf7-GFP) | Vacuole (Sac6-tdTomato) |
|---|
| Gene | Images |
|---|
| Gene | Images |
|---|
Images are not yet available
Images are not yet available